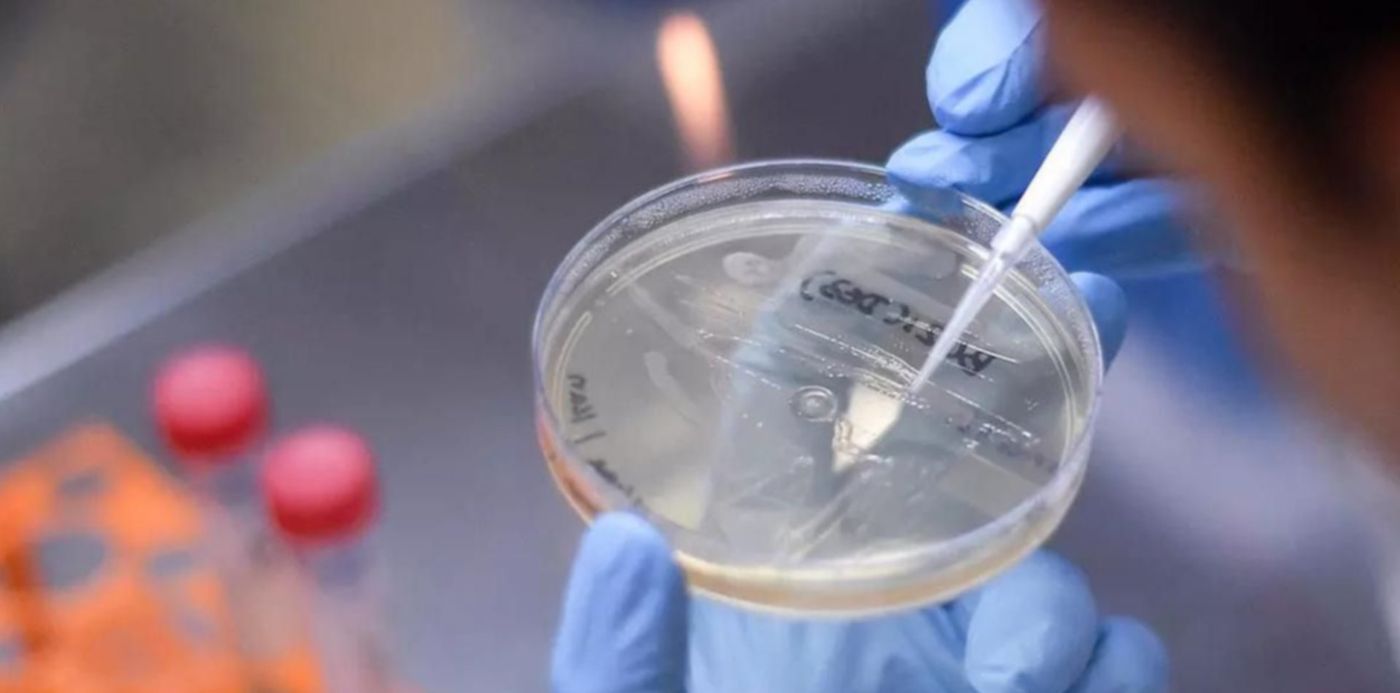
Cepa delta covid

El Ministerio de Salud de la nación dio a conocer el primer informe de noviembre sobre la situación de nuevas variantes del SARS-CoV-2 en el país y reveló que la detección de la variante Delta dio a un salto a nivel nacional que supera el 40%: de hallarse en el 26% de las secuencias genómicas de finales de septiembre saltó al 63% casi un mes más tarde. Las autoridades sanitarias indicaron que otras variantes de preocupación (VOC), como la Alpha y la Gamma; y de interés (VOI), como la Lambda; registraron caídas de hasta casi el 50%.
"En la búsqueda activa de casos de variante Delta (linaje B.1.617.2) se detectaron 716 casos no relacionados con la importación o en investigación en las siguientes jurisdicciones: Ciudad de Buenos Aires, provincia de Buenos Aires, Córdoba, Corrientes, Mendoza, Neuquén, Río Negro, Salta, Santa Fe, Santiago del Estero y Tucumán", sostiene el documento que tiene como fecha de cierre parcial el 25 de octubre pasado.
El escrito destaca que "en las últimas semanas del periodo analizado, la Delta (B.617.2) registró un ascenso que pasa de un 26% a alrededor de un 63%", mientras que Gamma (Manaos) pasó del 58.5% al 27.6% y Alpha (británica) descendió hasta representar menos del 1% de los casos. En el mismo sentido, la mutación Lambda (o andina) mostró una retracción que fue del 15% al 9% en la SE41. El estudio también advirtieron que, según la información aportada al Sistema Nacional de Vigilancia de la Salud (SNVS.2.0) por cinco Jurisdicciones del país, se podría estimar que "la proporción de casos probables de Delta entre las muestras analizadas en no viajeros se incrementó de un 33.7% a un 76.8%".
En los momentos en los que cayeron las restricciones en el ingreso al país por parte de turistas internacionales y los cupos pasaron a ser medidas del pasado, el Ministerio de Salud argentino detectó que de las "939 muestras de viajeros provenientes del exterior que ingresaron al país y que tuvieron resultados positivos o casos relacionados con la importación, desde el mes de enero hasta el 25/10, en 596 casos se halló la variante Delta".

De ese total, en 140 casos se identificó la variante Gamma y en 69 la Alpha. Mientras que entre las de interés, en 29 personas infectadas se aisló la Lambda y en 13 la recientemente caracterizada, y sumada a la lista de la OMS, Mu (colombiana), la cual fue identificada en viajeros provenientes de Colombia, Venezuela y México.

Una de las estrategias más importantes del Gobierno es impulsar la vacunación con dos dosis. Sin embargo, ningún suero es infalible y existe un pequeño porcentaje de personas que, pese a contar con el esquema completo, contraerán la enfermedad. En este aspecto, los científicos argentinos señalaron que:
-
Los vacunados con dos dosis: sobre un total de 1854 casos, un 54.2% se contagió gracias a la VOC Gamma, un 20% a la VOI Lambda, un 17.8% a la VOC Delta, 3.5% a la VOC Alpha y un 0.3% a la VOI Mu.
Con inmunización parcial (una sola dosis): de 1623 casos, un 61.7% corresponde a la VOC Gamma, un 23.2% a la VOI Lambda, un 8% a la VOC Delta, un 5% a la VOC Alpha y un 0.4% a la VOI Mu.
"La distribución de la proporción de variantes prioritarias es de 72% para los casos estudiados no inmunizados y de 74.6% para aquellos con inmunización parcial, mientras que en los casos analizados para la detección de variantes de SARS-CoV-2 con esquema completo de vacunación, la proporción de VOC es de 75.5%", cierra el trabajo.